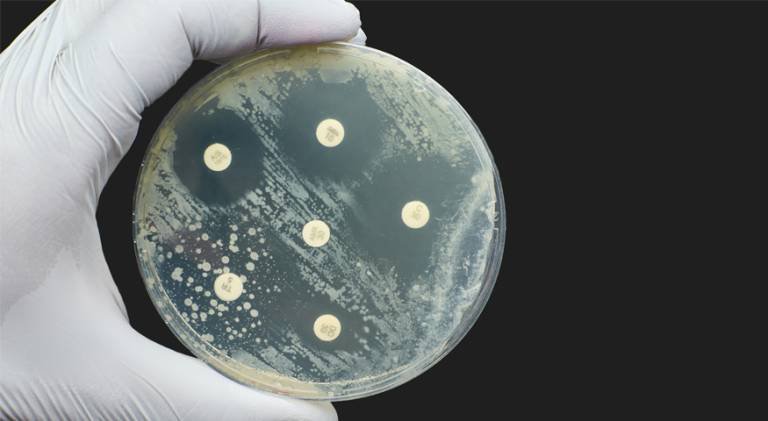
amr-hub-our-work.jpg

Grow Your Skills
We're committed to building the next generation of leaders in digital health and antimicrobial resistance. Through training, mentoring, and hands-on learning opportunities, we aim to support researchers, professionals, and students from all backgrounds to develop their skills and grow their careers. Our goal is to grow the interdisciplinary skills, capacity, knowledge sharing, and leadership needed to deliver a world-leading digital health strategy for combatting AMR.
Training Opportunities
We offer a training bursary to fund up to places on a range of training courses across our partner institutions. These courses are designed to help individuals build technical, scientific, and commercial expertise in key areas related to AMR and digital health. Opportunities include:
Programming and AI foundations
Translating AMR research into patents and products
Digital Health and Entrepreneurship
We also promote and signpost existing AMR education programmes delivered by other organisations, such as charities and healthcare providers - aimed at both professionals and the public. Be sure to visit this page to find out about upcoming courses.
What’s Been Happening?
We’ve been running and supporting exciting training opportunities across the UK - explore some of our recent highlights below.